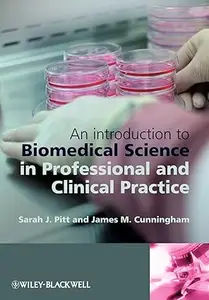
An Introduction to Biomedical Science in Professional and Clinical Practice

From Attention to Goaldirected Behavior Neurodynamical Methodological And Clinical Trends
«Toddlers: The Practical Guide to Overcome Behavior Problems & Tantrums and Raising a Happy Child» by Phoenix C. School Audiobooks
Posted by Gelsomino at Aug. 26, 2020
«Toddlers: The Practical Guide to Overcome Behavior Problems & Tantrums and Raising a Happy Child» by Phoenix C. School
English | MP3@192 kbps | 25 min | 35.1 MB
English | MP3@192 kbps | 25 min | 35.1 MB
An Introduction to Biomedical Science in Professional and Clinical Practice eBooks & eLearning
Posted by fdts at Oct. 21, 2014
An Introduction to Biomedical Science in Professional and Clinical Practice
by Sarah Jane Pitt, Jim Cunningham
English | 2009 | ISBN: 0470057157 | 240 pages | PDF | 5.9 MB
by Sarah Jane Pitt, Jim Cunningham
English | 2009 | ISBN: 0470057157 | 240 pages | PDF | 5.9 MB
Battery Technology: From Fundamentals to Thermal Behavior and Management eBooks & eLearning
Posted by yoyoloit at Feb. 10, 2023
Battery Technology
by A Rosen, Marc A.;Farsi, Aida;A Rosen, Marc A.;Farsi, Aida;, Aida Farsi
English | 2023 | ISBN: 0443188629 | 261 pages | True EPUB | 27.06 MB
by A Rosen, Marc A.;Farsi, Aida;A Rosen, Marc A.;Farsi, Aida;, Aida Farsi
English | 2023 | ISBN: 0443188629 | 261 pages | True EPUB | 27.06 MB
How to Analyze People with Dark Psychology: The Complete Guide to Human Behavior, Personality types and Manipulation. eBooks & eLearning
Posted by naag at July 2, 2025
How to Analyze People with Dark Psychology: The Complete Guide to Human Behavior, Personality types and Manipulation. Techniques to Speed Reading People & Influence Anyone using Body Language
English | 2022 | ASIN: B0BHDVRP1N | 109 pages | Epub | 836.32 KB
English | 2022 | ASIN: B0BHDVRP1N | 109 pages | Epub | 836.32 KB
From madness to mental health : psychiatric disorder and its treatment in Western civilization eBooks & eLearning
Posted by insetes at Dec. 8, 2021
From madness to mental health : psychiatric disorder and its treatment in Western civilization By Greg Eghigian & Gail Hornstein
2010 | 456 Pages | ISBN: 0813546656 | PDF | 3 MB
2010 | 456 Pages | ISBN: 0813546656 | PDF | 3 MB
An Introduction to Biomedical Science in Professional and Clinical Practice eBooks & eLearning
Posted by step778 at Jan. 17, 2025
Jim Cunningham, "An Introduction to Biomedical Science in Professional and Clinical Practice"
English | 2009 | pages: 240 | ISBN: 0470057157 | PDF | 4,3 mb
English | 2009 | pages: 240 | ISBN: 0470057157 | PDF | 4,3 mb
What Every Therapist Ought to Know: Attachment, Arousal Regulation, and Clinical Techniques in Couple Therapy [Audiobook] Audiobooks
Posted by IrGens at Jan. 31, 2022
What Every Therapist Ought to Know: Attachment, Arousal Regulation, and Clinical Techniques in Couple Therapy [Audiobook]
English | October 26, 2021 | ASIN: B09GX6WN2N | M4B@128 kbps | 9h 29m | 517 MB
Author and Narrator: Stan Tatkin PsyD MFT
English | October 26, 2021 | ASIN: B09GX6WN2N | M4B@128 kbps | 9h 29m | 517 MB
Author and Narrator: Stan Tatkin PsyD MFT
Introduction to Medical Imaging: Physics, Engineering and Clinical Applications (repost) eBooks & eLearning
Posted by roxul at July 7, 2017
Nadine Barrie Smith, Andrew Webb, "Introduction to Medical Imaging: Physics, Engineering and Clinical Applications"
2011 | ISBN-10: 0521190657 | 297 pages | PDF | 5 MB
2011 | ISBN-10: 0521190657 | 297 pages | PDF | 5 MB
Introduction to Medical Imaging: Physics, Engineering and Clinical Applications eBooks & eLearning
Posted by arundhati at May 25, 2014
Nadine Barrie Smith, Andrew Webb, "Introduction to Medical Imaging: Physics, Engineering and Clinical Applications"
2011 | ISBN-10: 0521190657 | 297 pages | PDF | 5 MB
2011 | ISBN-10: 0521190657 | 297 pages | PDF | 5 MB
What Every Therapist Ought to Know: Attachment, Arousal Regulation, and Clinical Techniques in Couple Therapy [Audiobook] Audiobooks
Posted by TheInsertus at March 19, 2023
What Every Therapist Ought to Know: Attachment, Arousal Regulation, and Clinical Techniques in Couple Therapy [Audiobook]
English | October 26, 2021 | ASIN: B09GX6WN2N | M4B@125 kbps | 9h 29m | 517.09 MB
Author: Stan Tatkin PsyD MFT
Narrator: Stan Tatkin PsyD MFT

![What Every Therapist Ought to Know: Attachment, Arousal Regulation, and Clinical Techniques in Couple Therapy [Audiobook]](https://pixhost.icu/avaxhome/58/51/008c5158_medium.jpg)

![What Every Therapist Ought to Know: Attachment, Arousal Regulation, and Clinical Techniques in Couple Therapy [Audiobook]](https://pixhost.icu/avaxhome/6c/10/009c106c_medium.jpg)